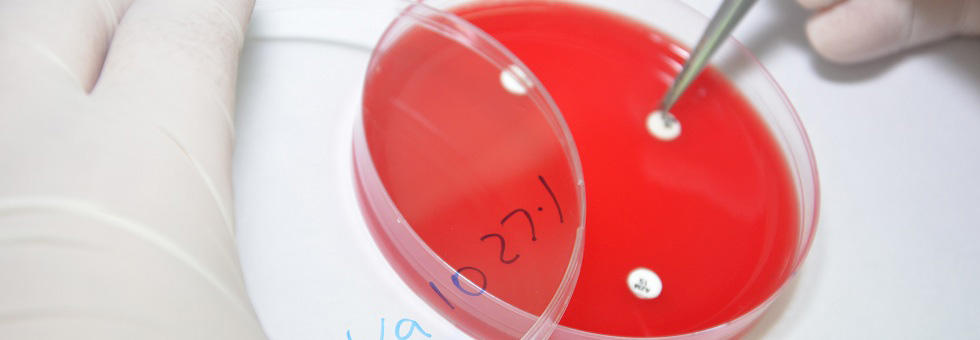
Четврти слајдер

ЈУ Ветеринарски институт Републике Српске „Др Васо Бутозан“ Бања Лука (ЈУ ВИРСВБ) је јединствена, национална, специјалистичка и научна институција ветеринарске медицине чија се форма, облик и стручни профил обликовао кроз деценије упорног и стрпљивог рада. Протекли вишедеценијски период су обиљежили бројни ентузијасти, стручњаци високог профила, који су за основно начело свога рада постављали искључиво стандарде струке. Континуирани развој се базирао на стварним потребама праксе и захтјевима савремених лабораторијских достигнућа. Примјена егзактних метода за потврду сумњи на одређене болести животиња и зооноза, контрола исправности и безбједности намирница анималног порекла и сточне хране је стални задатак и обавеза Института. Данашњи и будући захтјеви базирани на новим ставовима и стандардима по питању дефиниције здравља обавезују Ветеринарски институт Републике Српске да још снажније и одговорније прихвати изазове и постане сигурна и респектабилна институција у ланцу европских и свјетских референтних лабораторија, афирмишући своје и интересе своје земље. Ветеринарски институт има 60 запослених од којих је 30 високо образованих, који су задужени да сваки дан брину о здрављу грађана Републике Српске. Поред сједишта у Бањалуци, Институт има и лабораторију у Бијељини која је успостављена са циљем да се што прије приме и обраде достављени узорци из припадајуће регије. Лабораторије Института опремљене су савременом лабораторијском опремом за дијагностику заразних болести животиња, микробиолошке и квалитативне анализе хране и хране за животиње.
КЛИКОМ НА ФОТОГРАФИЈУ ИСПОД ДОБИЋЕТЕ ВИШЕ ИНФОРМАЦИЈА О УЛОЗИ ВИРСВБ У ЗАШТИТИ ЗДРАВЉА ЖИВОТИЊА И БЕЗБЈЕДНОСТИ ХРАНЕ